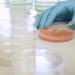
OMS alertó de un resurgimiento de los casos globales de cólera 10 cholerae

Este viernes 22 de septiembre, se lanzó a nivel nacional el Plan «Mi Mesa, Silla Bella», con la acción de las Bricomiles, Inces y FEDE, que permitirá recuperar el mobiliario de las aulas de clases que albergará a los estudiantes en el nuevo año escolar 2023-2024.
Con el objetivo de ofrecer mayor comodidad a los alumnos que regresarán a clases, el Ministerio del Poder Popular para la Educación realizó el lanzamiento del Plan «Mi Mesa, Silla Bella», destinado a recuperar los mobiliarios escolares.
En Monagas, Carolina Estaba, directora del Centro de Desarrollo de la Calidad Educativa (CDCE), desde la Escuela Técnica (ET) Maturín, «Prof. Luis Caballero Mejias», ubicada en la parroquia Las Cocuizas, detalló que en la entidad serán recuperadas más de 6 mil mesas y sillas de los planteles.
«Este plan es posible gracias a la unión cívico-militar de quienes voluntariamente conforman las Brigadas Comunitarias Militares para la Educación y Salud (Bricomiles), con la orientación de los maestros de las unidades curriculares de carpintería y herrería del Instituto Nacional de Capacitación y Educación Socialista (Inces), y la dotación de insumos por parte de la Fundación de Edificaciones y Dotaciones Educativas (FEDE)», agregó la autoridad educativa.
En la Escuela Técnica estuvieron acompañando al personal ministerial para dar su respaldo al plan, María Fagundez, Secretaría de Educación de la Gobernación de Monagas, el general (FANB) Marlon Hernández, comandante de la 63 Brigada de Construcción y Mantenimiento «José Aguerrederi Echenique»; Jackson González, gerente regional del Inces, Yonnaidis Subero, coordinadora estadal de FEDE y Fredy Fuentes, director de la Escuela Técnica Maturín.
En dicho plantel en una primera fase serán recuperados 350 mesas y sillas, así lo manifestó el director quien celebró el surgimiento de este proceso orientado por la ministra Yelitze Santaella, cómo parte del Plan Victoria Bicentenaria, que contempla los vértices de acción para el año escolar 2023-2024.
Unión de fuerzas
El gerente del Inces manifestó que el plan de amor involucra la participación del personal educativo y los miembros de las comunidades que de manera voluntaria se sumarán a las jornadas de trabajo.
«La idea es que en las escuelas y en los espacios comunitarios los maestros del Inces enseñen a trabajar la madera, y los procedimientos para soldar y adecuar las estructuras metálicas, logrando recuperar mesas y sillas para la comodidad de los estudiantes», explicó González.
Por su parte, la coordinadora estadal de FEDE resaltó que desde esta instancia los planteles recibirán los insumos para trabajar como: pintura, madera, tornillos, soldaduras, etc.

El plan es posible gracias a la unión cívico-militar de quienes voluntariamente conforman las Brigadas Comunitarias Militares para la Educación y Salud (Bricomiles)
Prensa CDCE Monagas
Entérate también: Alcaldía de Maturín contabiliza 8.638 toneladas de desechos sólidos recolectados entre agosto y septiembre